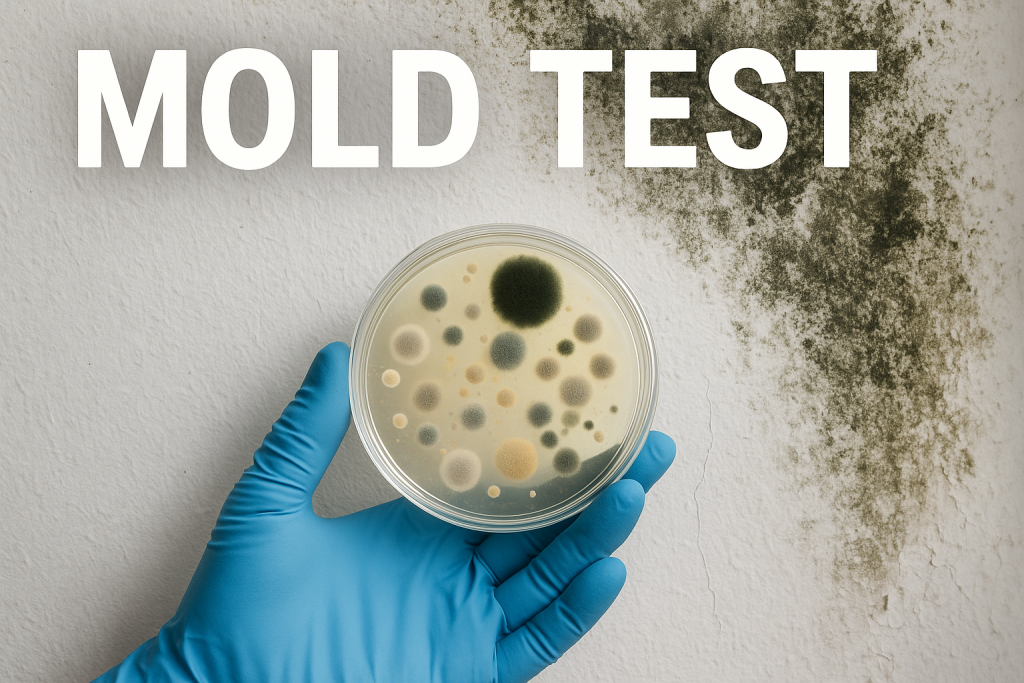

Наш первый продукт — зерновой мицелий, тщательно разработанный на основе сочетания высококачественных американских штаммов и экспертного опыта специалистов в области органического земледелия. Строгий контроль на каждом этапе производства и научно обоснованный подход гарантируют стабильность и эффективность продукта. BlackHyph предлагает инновационное решение для тех, кто ценит качество и натуральность.

Микология и грибоводство
Вдохновляйтесь природой и раскрывайте её секреты с помощью микологии. BlackHyph объединяет науку, инновации и грибоводство, предлагая лучшее для исследователей, энтузиастов и профессионалов.
Статьи к прочтению
Тест на плесень в домашних условиях: назначение и методы
07.11.2025
Комментариев нет
Ежовик гребенчатый | Полноценный обзор.
22.06.2025
Комментариев нет
Сотрудничество с нами
Мы открыты к сотрудничеству с оптовыми покупателями, исследовательскими лабораториями, научными проектами, а также представителями медиа и блогосферы.